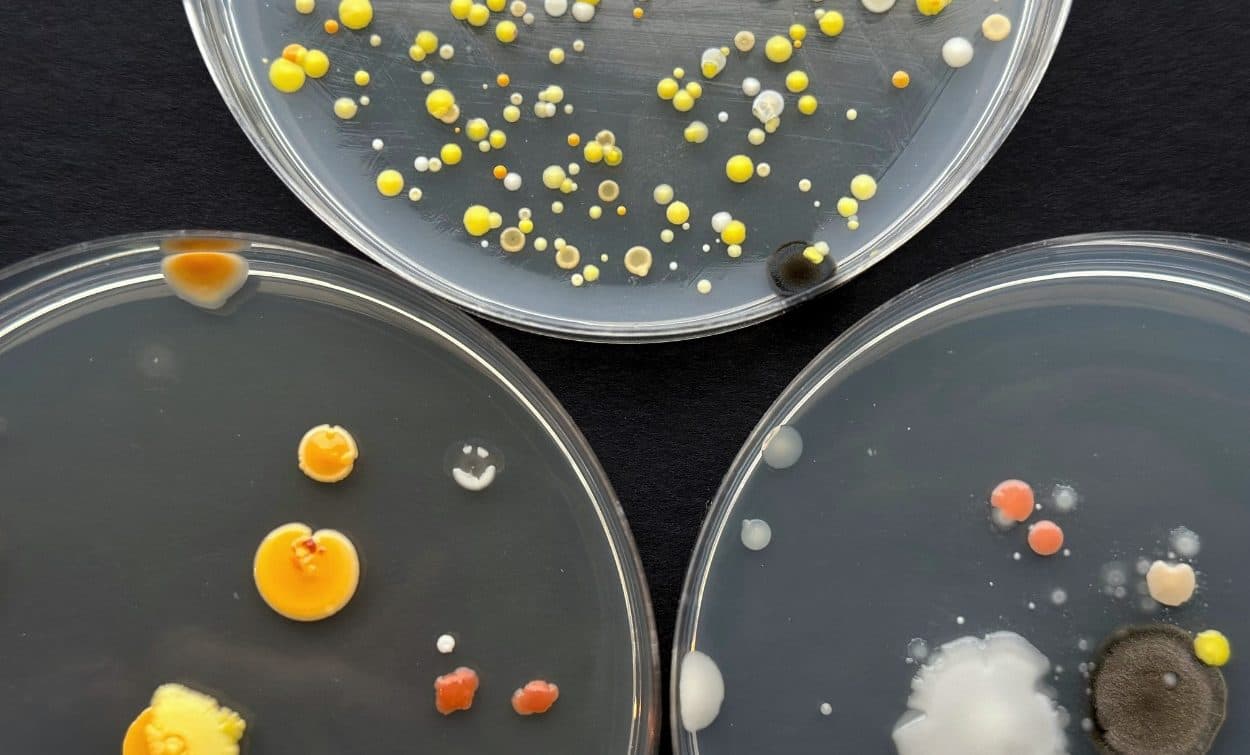

Ongoing

Bits and pieces from the workshop

Flétta

Einar Þorsteinn Ásgeirsson

Hönnunarsafnið sem heimili
Coming up

Órói

Lauf / Bike ride
Past Exhibitions

Best Book Design from all over the world and The Icelandic book design awards

Trausti Valsson – Color, Ornament and Zest for life
The Dream Village

Tinna Gunnarsdóttir

Gallery Bosom

Archiving Vík Prjónsdóttir

KE&PB

Paper dolls – Fashion Designers of the Future

Animated Geology
Brynjar Sigurðarson

Barbie goes to The Design Museum

Best book design from all over the world

Unndór Egill Jónsson

Þórunn Árnadóttir product designer

Home textiles

Unnar Ari Baldvinsson
Graphic designer

Microbes in the home

Wool

Archiving the work of graphic designer Gísli B. Björnsson
Napkins
29 designers

Guðrún Pétursdóttir
Basket weaver

Straws and Branches

Fireflowers
When dance becomes product design

Jewellery

Marta Staworowska
Goldsmith

The most beautiful books in the world

Messages

Dolinda Tanner
keramik og textílverk

Lothar Grund, archiving drawings

Lilý Erla Adamsdóttir

Nína Gautadóttir
Textile artist

NÆRVERA
New sweaters by Ýrúrarí

HABITATIONS

THE BEST BOOK DESIGN FROM ALL OVER THE WORLD 2022

Ada Stańczak
Ceramic designer

H A G E
Master Milliners

MODELMAKERS IN RESIDENCY

VIRTUAL WATERS

Bathing Culture

STUDIO ALLSBER
Product designers

BEST BOOK DESIGN FROM ALL OVER THE WORLD 2021 AND 2020

ARCHIVING ARCHITECTURAL DRAWINGS OF HÖGNA SIGURÐARDÓTTIR

Sunna Örlygsdóttir
Fashion designer

Sveinbjörn Gunnarsson
Modelmaker

KRISTÍN ÞORKELSDÓTTIR
graphic design became my destiny

NATURAL DYES: A MODERN PERSPECTIVE

SVEINN KJARVAL – QUALITY IS NEVER AN ACCIDENT

DEIGLUMÓR
Ceramics from icelandic clay 1930–1970

Ýrúrarí
Textile designer

CONSERVING AND ARCHIVING TEXTILE WORK

100% WOOL

Sigurbjörn Helgason
Bird artist

FLOKK TILL YOU DROP

PAPERFLOWERS – RÚNA ÞORKELSDÓTTIR

ICELANDIC VISUAL LANGUAGE –STUDIO

ÁSTHILDUR MAGNÚSDÓTTIR
Weaver

ANNA MARÍA PITT
Jewellery artist

Archiving a ceramic collection

Shu Yi
Designer

URBAN SHAPE
Paolo Gianfrancesco

100ÁR100HLUTIR

AND ANTI MATTER
Creative studio

Torfi Fannar
Fashion designer

THE IMAGINARIUM OF KRON BY KRONKRON

EINAR ÞORSTEINN

THE ICELANDIC WOOL SWEATER
Origin, History and Design

Hanna Jónsdóttir
Product designer

ICELANDIC RECORD COVERS

NORDIC ANGAN – FRAGRANCE LIBRARY
Designers

CHAIR

ON PAPER

GARÐABÆR’S TOWN CREST

TRIAD
Three designers strike a chord on DesignMarch 2016

ICELAND IS SO CERAMIC
a retrospective of Steinunn Marteinsdóttir’s ceramic works

ÁMUNDI:

UN PEU PLUS
Helga Björnsson

PRÝÐI

THIS IS HOW I DO IT
Hjalti Karlsson

HEIMAR – KOSMOS

ARE YOU READY, MADAM PRESIDENT?

PARADIGM